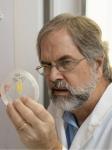

Editor in Cheif
-
Prof. Nadia Zikry Dimetry Mail National Research Centre, EgyptPersonal ID: Scopus: https://www.scopus.com/authid/detail.uri?authorId=6603398780 ORCID: https://orcid.org/0000-0002-2696-9245 1- A member in the editorial board in Journal of Plant Science ( International Journal of Natural Resource Ecology and Management since 9 February, 2018- Feb. 2020 2- International Member in the Society of Biopesticide Sciences India since 1997 3- International member of the American Association for the advancement of Science (AAAS )in the year 1993 4-Member in the Editorial board of the National Research Centre Bulletin, Cairo, Egypt from 1988 till 2000 5 -An active member in the Egyptian Society for Biological Control of Pests ((ESBCP) since 1996. 6-Associate Editor in-chief of Basic Research Journal of Agricultural Science Review ( BRJASR) on 1st July 2012.
Associate Editor-in-Chief
-
Prof. Anna Maria Vettraino University of Tuscia, ItalyDr Anna Maria Vettraino is Professor at the Department for Innovation in Biological, Agro-food and Forest systems (DIBAF). She got her first degree in Agriculture (1991) and a PhD on Mycrobiology (1996) and a PhD on Plant Protection (2003) at University of Tuscia. She has been assigned with several fellowships at national and international Institutes (University of Tuscia, University of Bari, Hebrew University, Michigan State University, Institute of Forest Botany-Freising, University of Berkeley, Murdoch University, Department of Plant Protection Messeweg-Braunschweig). Her research field is the biology, the ecology and genetics of beneficial and detrimental microorganisms in natural ecosystems, forestry and agricultural fields. Her research is focused on the development of new detection methods for fungi and bacteria, including the Next Generation Sequencing approaches. She is co-author of more than 200 scientific publications, and 7 book chapters. She participated at several National (CARBOITALY, VIVABIO, PRIN, Parco Nazionale Gran Sasso Monti della Laga, Assam, Aquaser), European and International research projects (also as coordinator) (CASCADE, PATHOAK,BACCARA, ISEFOR, CARBIUS, FAO_Nepal, USDA, MIUR_Algeria, Murdoch University). She is Editorial Board member of Pathogens (ISSN 2076-0817). Editorial Board Member in Pathogens for section 'Fungal Pathogens' Forests (ISSN 1999-4907). Editorial Board in Forests for section 'Forest Health' Frontiers (ISSN 2624-893X) Editorial Board in in Forests and Global Change Journal of Plant Pathology(ISSN11254653) Editorial Board She is editor of special Issue: - Pathogens (ISSN 2076-0817) Special Issue "Advances and Challenges in Understanding and Management of Diseases Caused by Oomycetes"; (Guest editors Dr. Anna Maria Vettraino, Dr. Benedetto T. Linaldeddu) - Forests (ISSN 1999-4907). Special Issue "Managing Indoor Wood Biodeterioration" (Guest editors Dr. Anna Maria Vettraino, Dr. Luisa Ghelardini, - Microorganisms (ISSN 2076-2607).Title: Oomycetes Associated with Urban and Natural Forests: From the Past to the FutureL; Website: https://www.mdpi.com/si/165119 (Guest editors Dr. Diana Marčiulynienė , Dr. Anna Maria Vettraino)
Editorial Board Member
-
Dr. Pasco B. Avery University of Florida , United StatesDr. Avery’s more than a decade of experience and knowledge for management of invasive and domestic arthropod pests of horticultural crops has included trials with vegetables, citrus and avocado trees, ornamental plants, and floriculture. To achieve his unique systems approach, he has used and applied molecular tools for determining genetic biodiversity and the presence of various entomopathogenic fungi of insects in the soil. In his current role, he is conducting research involved in applied ecology, entomology, and insect pathology, evaluating multi-trophic interactions between host plant-pest-pathogen/parasitoids from a systems approach. His work is specialized to meet crop protection and production needs for growers of tropical and subtropical crops including citrus, avocado and ornamentals. As a research scientist, he has both instructed and investigated the impacts and effects of chemical pesticides or biocontrol agents on target and non-target organisms. He has designed projects investigating the subsequent risk analysis and quarantine tests required prior to releasing a non-native species into a foreign environment as well as within restoration scenarios. These tasks involve the coordination of international and domestic multidisciplinary collaborative research partners. Dr. Avery has authored or co-authored more than 60 publications appearing in peer-reviewed journals for which more than 1,000 citations collectively have been made. Additionally, he has contributed to more than 30 extension-related publications.
-
Dr. Cecilia Brunetti National Research Council of Italy, ItalyEDUCATIONAL QUALIFICATIONS: 2021- Senior Researcher, National Research Council (CNR), Institute for Sustainable Plant Protection (IPSP) 2018-2021 Researcher, National Research Council (CNR), Trees and Timber Institute (IVALSA) 2015-2018 Postdoctoral fellow, National Research Council (CNR), Trees and Timber Institute (IVALSA) 2015 PhD, Agricultural Science, University of Florence 2011 Fellowship for graduate students, University of Florence, Department of Agriculture, Environment, Food and Forestry 2011 BSc, Agricultural Sciences, University of Florence 2000 MSc, Pharmaceutical Chemistry and Technology, University of Florence CURRENT RESEARCH INTERESTS: The main objective of my research is to study physiological and biochemical responses of plants to environmental stresses, in particularly to investigate the mechanisms of drought-induced tree mortality. Current research interests are: Effects of climate change on photosynthesis and plant primary metabolism Emission of biogenic volatile organic compounds (BVOCs) under abiotic and biotic stresses Impact of drought on plant water relations and hydraulic traits Use of leaf proximal sensors to measure leaf water content Plant metabolomics to investigate chemical footprints in plant tissues and fruits under different environmental conditions KEYWORDS: Environmental stress; Metabolomics; Plant/soil interaction; Photosynthesis; Plant ecophysiology; Plant secondary metabolism BIBLIOMETRIC INDEXES: Total number of publications in peer-review journals: 84 (Scopus 04/05/2023) Total number of citations: 3422 (Scopus 04/05/2023) H index: 31 (Scopus 04/05/2023)
-
Dr. Dusica Ilic University of Niš, SerbiaDusica Ilic's work and scientific activity are an important contribution to science in the field of synthesis of substances, as well as in the field of separation of bioactive substances from plant raw materials, in the field of organic chemistry, phytopharmaceutical preparations, drug carriers, chemical synthesis, characterization of natural and synthetic organic compounds in the field of development of new information-communication technologies, using mathematical methods, with applications in medicine, energy and telecommunications, e-government and protection of national heritage, as well as in wastewater treatment. In addition to the scientific contribution, the results of Dr Dušica Ilic have the applicative significance for designing optimal technological procedures with practical application. Dr. Dusica Ilic had a high professional level in the course of work according to teaching and non-teaching obligations. Dr Dusica Ilic expresses the ability for teamwork and collegiality, is ambitious, ready for new knowledge, learning and professional work.
-
Prof. Khalid Ahmed National Research Centre, EgyptDr. Khalid A. Khalid is a Professor and head of Medicinal and Aromatic plants Department, Pharmaceutical and Drug Industries Institute, National Research Centre, Egypt. He earned his BSC (1990) in horticultural sciences. After he graduated Faculty of Agriculture, Ain Shams University he started his academic carrier in 1992 at National Research Centre (NRC) working on cultivation and production of medicinal and aromatic plants. In 1997 and 2001, he earned his MSC and PhD in Medicinal and Aromatic Plants from Faculty of Agriculture, Al-Azhar and Ain Shams Universities. After he earned his PhD, his research focused on production Medicinal and Aromatic Plants under different environmental factors. Also He earned postdoctoral research (2007-2008) from Shanghai Institute of Plant Physiology and Ecology, Chinese Academy of Sciences, China. His research also focused on isolation and characterization of the constituents of essential oil bearing plants and post harvest treatments.
-
Prof. Zienab Ahmed United Arab Emirates University, United Arab EmiratesI have spent my career to date working in academic and research institutions since I graduated with a BSc. in Horticulture Science from Assiut University, Egypt, and then a master’s degree in 2005 from the same University. I worked as an assistant teacher/researcher at South Valley University, Egypt before I was awarded a Ph.D. scholarship from the Egyptian Government in 2009. I earned my Ph.D. in Horticulture physiology and biochemistry from the Horticulture Department, College of Agriculture and Life Science, University of Wisconsin-Madison (UW), WI, USA in 2014. I was also awarded a research/teaching assistantship from UW University for one year in 2014. Back to Egypt in 2015 to work as an assistant professor at Horticulture Department, South Valley University till August 2019, before commencing my current position at The United Arab Emirates University (UAEU) as an assistant professor in the Integrative Agriculture Department, College of Agriculture and Veterinary Medicine. I have been teaching several courses under/grade plus supervising several senior, master, and Ph.D. students. I also established a Horticulture physiology postharvest technology research lab and led two newly established greenhouses and fruit tree orchards in Al Maqam Campus. I also contributed to several services and events at the Department and College levels. In addition to that, I published in peer-reviewed Scopus journals, and also reviewed and edited for many Scientific journals in the field. I presented our research activities at several national and international conferences and professional workshops. I was successfully awarded several internal and external research grants. My achievements contribute through international outreach and networking in becoming a leader in the fields of Horticulture crop production and physiology through high-quality teaching and active engagement in acquiring research funds.
-
Dr. Camelia Ungureanu University Politehnica of Bucharest, RomaniaAssociate professor The National University of Science and Technology POLITEHNICA Bucharest, Faculty of Chemical Engineering and Biotechnologies, 1 Polizu Street, Bucharest, http://www.chim.upb.ro process supervisor/teaching and research Activity sector: Education Areas of Expertise Bioengineering&Chemical Engineering Agronomy Food Chemistry Reviewer for Coatings, Materials, Nanomaterials, Journal of Environmental Management (Elsevier Press); Chemical Engineering Communications (CEC); The ninth International Conference on Chemical & Process Engineering; Journal of Medicinal Plants Research; Journal of Petroleum Technology and Alternative Fuels, JPTAF; ICheaP10 International, International Conference on Chemical & Process Engineering; 3rd International Conference on Machine Learning and Computing (ICMLC 2011); Materials Science and Engineering: C, Materials for Biological Applications, (Elsevier Press); African Journal of Microbiology Research; U.P.B. Sci. Bull., Series B; Sun and Geosphere; International research journal of biotechnology; African Journal of Agricultural Research; International Research Journal of Agricultural Science and Soil Science; Journal of Research in Environmental Science and Toxicology; Herald Journal of Microbiology and Biotechnology – member in Editorial Board; Basic Research Journal of Agricultural Science Review; International Journal of Agricultural Science Research; Sky Journal of Journal of Microbiology Research; Academia Journal of Biotechnology; Webpub Journal of Agricultural Research; International Scholars Journals; WebPub Journal of Scientific Research, Greener Journals, African Journal of Pure and Applied Chemistry.
-
Dr. Anita Ierna Consiglio Nazionale delle Ricerche, ItalySeed treatment, ecotype, aboveground biomass, flowering, ascorbic acid, sodium bisulphite, transpiration, antioxidant capacity, apigenin, leaf water potential, antioxidant activity, soil moisture content
-
Dr. Saddam Saqib Chinese Academy of Sciences, ChinaMr. Saddam Saqib currently works at the State Key Laboratory of Systematic and Evolutionary Botany, Institute of Botany, Chinese Academy of Sciences. Saddam does research in Microbiology, Botany, Agriculture, Tissue culture, Biotechnology and Molecular Plant Pathology. His current project is 'Systematics and Evolutionary history of flowering and medicinal plants. Specifically, he is investigating phylogeny and evolutionary history of Pan-Himalayan flora and Flora of Pakistan by using R. packages and online Bioinformatics tools. He completed his M.Phil. (MS) thesis from “Quaid-i-Azam University, Islamabad, Pakistan”. He is familiar with plant pathogen control and green synthesis applications against plant disease control. In addition, he has a good teaching background in prestigious universities of Pakistan. Saddam published more than 55 research articles in prestigious journals with about 100 impact factor and more than 1400 citations.
-
Prof of Botany, Excellence Center (EPCRS), Plant Patho. and Biotec. Lab.,Kafrelsheikh UniversityTrainer certified from IBCT (USA). Qulity manager of Excellence Center of Egyptian Phytomicrobial Collection for Research and Sustainability (EPCRS) (ISO 9001, 14001 and OHSAS 18001). Director of Plant Pathology and Biotechnology Lab. (certified ISO/ 17025). Qulity manager of Plant Pathology and Biotechnology Laboratory. Reviewer and editor in international Journals: Agronomy; Agriculture; Ecotoxicology and Environmental Safety; Horticulturae; International Journal of molecular science; International Journal of plant biology; Industrial crops and products; Plants; Plant growth regulation; Physiological and molecular plant pathology; Physiologiy and molecular biology of plants; Phytosynthetica; Phyton-International Journal of Experimental Botany; Rice Science; Sustainability; Sugar Tech
-
Prof. Baudilio Herrero Universidad de Valladolid, SpainI have worked as a professor in the Botany area for 30 years, teaching agricultural botany and biology. I have directed 50 final degree projects and 2 doctoral theses. editorial board experience. The Open Agricultural Journal Ecology of Food and Nutrition Annals of Agricultural Science International Journal of Agriculture Sciences International Journal of Molecular Sciences
-
Prof. Muhammad Faisal Manzoor South China University of Technology, ChinaMuhammad Faisal Manzoor (Food Science and Engineering) School of Food Science and Engineering, South China University of Technology, China/Foshan University, Foshan, China https://orcid.org/0000-0002-3705-0277 H-index=26, i10-Index=59 Professional Experience • Lecturer/Postdoctoral Fellow Sep-2022 to present School of Food Science and Engineering South China University of Technology, Guangzhou/Foshan University, Foshan, China • Postdoctoral Fellow Aug-2020 to July-2022 School of Food and Biological Engineering Jiangsu University, Zhenjiang, Jiangsu, China • Doctorate Fellow Sep-2017 to Jul-2020 School of Food Science and Engineering South China University of Technology, Guangzhou, China Merit scholarship for Ph.D. studies, Awarded by CSC Scholarship Council, China Editorial Board Membership and Reviewing Committee Membership: Associate Editor in Frontiers in Sustainable Food Systems (Frontiers) Academic Editor in Journal of Food Quality (Hindawi) Advisory Board Member in Heliyon (Elsevier) Guest Associate Editor (Polymers-MDPI) Guest Associate Editor (Molecules-MDPI) Guest Editor in Food Quality and Safety (Oxford Press) As a Reviewer in Journal of Food Biochemistry, Food Chemistry, International Journal of Biological Macromolecule, Carbohydrates polymer, Foods, Food Science and Nutrition, Heliyon, Gels, Beverages, and Journal of the Science of Food and Agriculture, Food Science and Technology, Journal of Food Processing and Preservation, International Journal of Food Science and Technology, Frontiers in Nutrition, Journal of Food Quality.
-
Dr. Luis A. Puente Universidad de Chile, ChileLuis Puente Diaz Associate Professor Universidad de Chile, Chemical and Pharmaceutical Sciences Faculty, Food Science and Chemical Technology Department. Dr. Luis Puente is a Food Engineer from Universidad Tecnologica Metropolitana, he has diplomas in curriculum innovation, packaging and innovation management. He did his Ph.D in the Department of Food Technology at the Polytechnic University of Valencia. He is currently an Associate Professor at the Faculty of Chemical and Pharmaceutical Sciences of the University of Chile. He has developed several activities in the field of teaching and university management at Universidad Tecnologica Metropolitana (1998-2010) and at Universidad de Chile (2010 to date) teaching courses in different undergraduate and graduate programs. He is currently a visiting professor at the University of Alberta-Canada (2023-2025). In the field of research, his main line of research is based on the application of various technological alternatives for the development of innovative combined drying processes with a view to obtaining stable and high-quality food products and ingredients, preserving their technological and functional properties to the maximum. In this context, the integral use of different raw materials and their by-products for the development of functional ingredients is also considered. It also includes the modeling of the operation in terms of the transfer of matter and energy aspects to scale and transfer the developments obtained to the local industry. The technologies included in the line are infrared-assisted hot air drying, refractory window drying and ultrasound-assisted osmotic drying. It also considers projecting towards other technological elements that allow accelerating and/or improving food dehydration processes. In addition to the above he was a scholarship holder of the Japan International Cooperation Agency (JICA) in the year 2006, carrying out the cooperation course Technical Support for SME I Biotechnology at the Municipal Research Institute of Technology of Osaka-Japan and a scholarship holder of the Ministry of Commerce of the Government of China in the course High Technology in Food Processing for Developing Countries taught by the Beijing Food Research Institute, finally he has been a scholarship holder of the Government of Egypt in the course "Project Analysis" taught by the Egyptian Intermational Centre for Agriculture in 2013. He is a member of the Chilean Society of Food Technology SOCHITAL, and the Chilean Society of Nutrition (SOCHINUT). He is associate editor of the food area in the Chilean Journal of Nutrition.
-
Prof. Nabil El-Wakeil Martin Luther University, GermanyBiological Control、Conservation of Natural enemies、Mass Production of Biocontr
-
Dr. Giuseppe Ferrara Università degli Studi di Bari, ItalyGiuseppe Ferrara has been working as Ph.D. Assoc. Prof. in the Department of Soil, Plant and Food Science at Bari University. His works deal: table grape, pomegranate, fig, pecan, pistachio, plant nutrition, precision irrigation, bud and flower biology. Prof. Giuseppe Ferrara is Editor for the following international journals: Frontiers in Plant Science, Plant Breeding section; Journal of Plant Sciences; American Journal of Agriculture and Forestry; Agriculture, Forestry and Fisheries.
-
Dr. Adem Gunes Erciyes University, TurkeyPhosphorus, soil fertility, soil, soil analysis, fertilisers, soil chemistry, plant nutrition
-
Prof. Kenan Turgut Akdeniz University, TurkeyPlant tissue culture, plant breeding, medicinal plants, plant biotechnology
-
Dr. Pedro Araújo State University of Campinas, BrazilPhD in Plant Biology from UNICAMP / Brazil. I focused on understanding lignin biosynthesis in model and commercial plants (sugarcane and Eucalyptus). This process can improve cell wall properties for biofuel production and derivatives.
-
Prof. Memnune Şengül Ataturk University, TurkeyProf. Dr. Memnune Şengül Memnune Şengül received her M.Sc. (Food Engineering) and Ph.D. (Food Engineering) degree in Department of Food Engineering, Ataturk University, Turkey. She is working as a Professor in Department of Food Engineering, Faculty of Agriculture, Ataturk University, 25240 Erzurum, Turkey. Prof. Sengul’s areas of research and work expertise are: fruit and vegetable processing technology, antioxidant activity, phenolic compounds, anthocyanins, medicinal and aromatic plants, aroma compounds in food, jam, marmalade, traditionally foods. She is an author or co-author of 55 peer reviewed journal research articles (41 in SCI or SCI expanded journal and 14 others), and over 50 national and international conference papers. She serving as a reviewer for numerous peer review journals.
-
Dr. Aslıhan Esringu Ataturk University, TurkeyAslıhan Esringu Department of Landscape Agriculture at Ataturk University, Turkey Aslıhan ESRİNGÜ has been working as Assoc. Prof. Dr. in the Department of Landscape Agriculture at Ataturk University. Her research interests include: Soil science, plant nutrition, fertilization, soil pollution, remediation and chemical analysis of soil and plant.
-
Prof. Mustafa Yildiz Ankara University, TurkeyMustafa Yildiz received his Ph.D. in 2000 from Ankara University, Turkey. He is currently working as a Professor in Ankara University, Faculty of Agriculture, Department of Field Crops. Prof. YILDIZ’s research areas include: plant tissue culture, plant biotechnology, molecular markers, Agrobacterium tumefaciens-mediated gene transfer, plant stress physiology, plant immune system, plant defense mechanism and plant breeding. Mustafa YILDIZ has scientific publications over 150, two books and 7 book chapters. He was awarded as 1st place in the “International Sunflower Project Market” by “International Sunflower Association” for his project titled “A New Environmental Friendly Production Method in Sunflower for High Seed and Crude Oil Yields”.